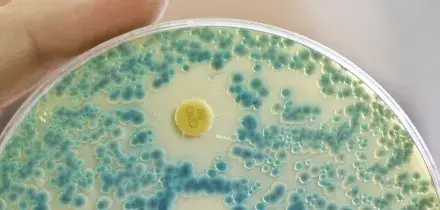
Che cos&rsquo;&egrave; la meningite tubercolare che ha colpito la bimba ricoverata a Bologna

s
Tutte le prime pagine di oggi su Giornalone.it

Bimba di 2 anni ricoverata a Bologna per meningite tubercolare
Oggi 04-02-26, 14:47
Il ricovero al Policlinico Sant’Orsola di Bologna è stato reso necessario dalle complicazioni di una meningite tubercolare, un’infezione rara e …
CONTINUA A LEGGERE

4

0

0
Sky Tg 24
16:49
Cassazione, la gelosia non attenua i reati di stalking
Sky Tg 24
16:35
Roma, rimosso il volto di Meloni dal dipinto a San Lorenzo
Sky Tg 24
16:35
Rapporto NAS 2025: quasi uno street food su due è irregolare
Sky Tg 24
16:35
Frana Niscemi, in campo gli esperti Ingv per il monitoraggio
Sky Tg 24
16:27